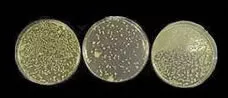

歯と身体の健康のために
当院は、定期管理予防型の歯科医院です
治療の繰り返しに、終止符を打ちませんか?
お電話でのご予約 0467-55-5204 ※ Web予約で空きがない場合も対応できる場合がございます。お急ぎの場合はお電話ください

当院は、定期管理予防型の歯科医院です
治療の繰り返しに、終止符を打ちませんか?

こんな風に考えている方も多いかもしれません。
これらは、すべて誤解です。
虫歯や歯周病を防ぎ、歯を失わない方法は既に確立されております。ですが、その方法を十分に理解している方はまだまだ少なく、その結果、多くの方が歯の健康を損なっています。
毎日の歯磨きだけでは、虫歯や歯周病の発生を完全には防げません。何故でしょうか?
それは、「定期的な歯科医院でのメンテナンス」を欠かしているからです。定期的なメンテナンスを受けることで、歯を守る効果があるという統計データをご紹介します。

こちらの統計グラフは、各国における『定期的な歯科医院でのメンテナンスの受診率』と『80歳の時に残っている歯の本数』との相関関係を示しています。グラフからは、定期的に歯のメンテナンスを受けることで、80歳の時に残る歯の本数が多いことが見て取れます。特に、日本では定期的なメンテナンスの受診率が低いため、80歳時の残存歯数が平均して8本しかないことがわかります。
では、なぜ歯科医院でのメンテナンスがこれほどまでに重要なのでしょうか?
それは、日常のブラッシングだけでは除去しきれない汚れ(歯石など)が存在するためです。これらの汚れは、歯科医院での専門的な機材を使わないと取り除くことができません。

当院での予防には、『定期検診』と『定期管理』の2つがあります。どちらも重要ですが、当院は特に『定期管理』を推奨しています。
口内の異常を早期に発見し、治療すること。
口内の健康を維持するため、定期的に管理し続けること。
『定期検診』は問題が起きたときに対応しますが、『定期管理』は問題が起きないよう予防します。これは、問題が起きてからでは遅いという考えに基づいています。
問題を未然に防ぎ、健康な状態を持続させるための『定期管理型の予防歯科』が、あなたの歯を長期的に守ります。

当院での口内の状態の検査と診断を通じて、各患者さんに最適な予防プログラムを立案します。

虫歯は口内の細菌、特に虫歯菌による感染症であり、再発防止には細菌の徹底的な除去と殺菌が非常に重要です。当院では、虫歯菌に対して強力な殺菌効果を持つ『口腔機能水(POIC)』を使用して、治療後の再発リスクを抑えます。
以下の画像は、口腔機能水を使用する前と使用後の状態を特殊な顕微鏡で撮影したものです。画像をご覧いただくと、使用後には細菌がほとんど死滅していることが確認できます。

PMTCとは、歯の着色やプラーク、歯石などを機械的に除去するクリーニングのことを指します。単なるクリーニングを超え、虫歯や歯周病が発生しにくい新しい口内環境を構築することが目的です。当院のPMTCは、以下のような状態の方に特に推奨されます。
当院では、「超音波スケーラー」「ハンドスケーラー」「エアフロー」などの治療器具を用いてPMTCを行います。

超音波スケーラーは、超音波の振動を利用して歯に付着した歯石(細菌の塊)を効率的に除去します。これにより、短時間で広範囲にわたる歯石を除去することができます。

ハンドスケーラーは、特殊な機材を使用せず、手作業で歯石(細菌の塊)を丁寧に除去します。これによって、細部までしっかりと歯石を除去できます。

エアーフローは超微粒子パウダーを吹き付けることで、歯周ポケット内の細菌を効果的に除去します。この方法では、歯の表面や歯茎、歯質を傷つけることなく、バイオフィルム(細菌の塊)を取り除くことが可能です。

高濃度フッ素は、歯科医院でのみ扱うことが可能な特別な予防材料です。通常のフッ素と比較して約18倍の濃度(9000ppm)を有し、その予防効果は非常に顕著です。高濃度フッ素を使用することで、口内の健康を長期的に保つ手助けをします。

PCRは、歯垢に反応する着色液を使用して、日常の歯磨きで磨き残された部分を染め出す方法です。この技術を用いることで、普段の歯磨きで磨けていない箇所が明確になり、より効果的なブラッシング方法を学ぶことができます。


当院の定期管理型予防歯科では、予防及び歯周病治療の専門家である歯科衛生士が中心となります。ここでは「担当制」を採用しており、一人ひとりの患者さんに専任の歯科衛生士が付きます。この制度により、患者さんの口内の健康状態や生活習慣を綿密に把握し、それに基づいた最適なメンテナンスプランを提供します。
当院では、患者さんが抱えていらっしゃるお口のお悩みや疑問・不安などにお応えする機会を設けております。どんなことでも構いませんので、私たちにお話ししていただけたらと思います。
ご興味がある方は下記からお問い合わせください。